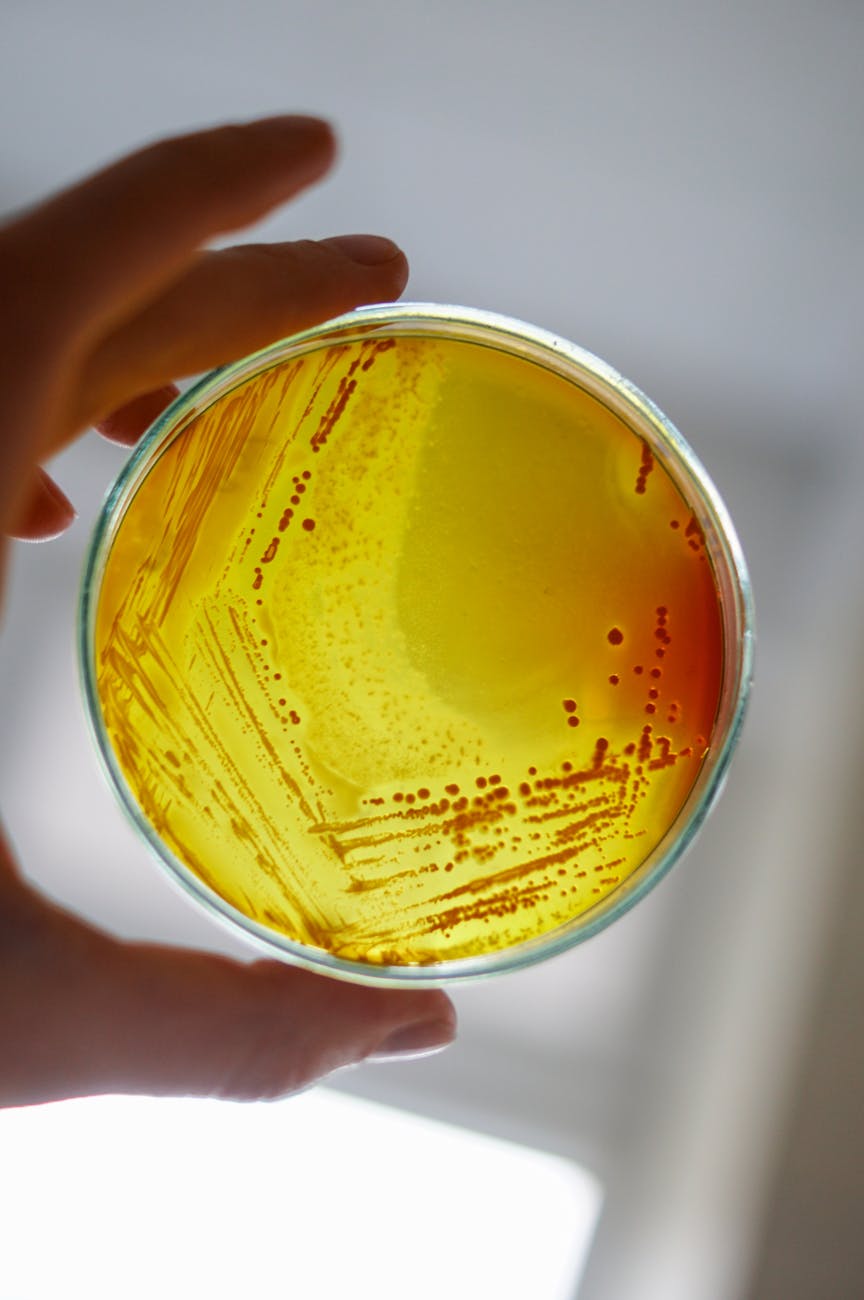
Microbiología de E. coli: Diagnóstico y Tratamiento

Categoría: Respuesta inmune
-
Microbiología de E. coli: Diagnóstico y Tratamiento
Escherichia coli: microbiología, patogenia, patotipos y clínica | InfectoVega Escherichia coli: microbiología, patogenia, patotipos y clínica 5 de octubre de 2025 · Lectura: 8–10 min · Por Dr. Agustín Vega De comensal a patógeno oportunista: cómo la virulencia define la clínica. Resumen E. coli es un bacilo Gram negativo del intestino humano. Produce diarreas, infecciones…
-
Entendiendo la Virulencia de Enterobacteriaceae en Infecciones Clínicas

Enterobacteriaceae: microbiología, virulencia y clínica (E. coli, Klebsiella, Enterobacter, Proteus, Serratia, Salmonella, Shigella) | InfectoVega Enterobacteriaceae: microbiología, virulencia y clínica (familia ampliada) 5 de octubre de 2025 · Lectura: 8–10 min · Por Dr. Agustín Vega De comensales a patógenos: claves de virulencia y su traducción clínica. Resumen Las Enterobacteriaceae son bacilos Gram negativos de…
-
Escherichia coli en adultos: de la microbiología a la clínica (LATAM/Colombia)

Guía práctica de Escherichia coli: microbiología, virulencia, inmunidad innata, transmisión, diagnóstico y perlas PROA en adultos (LATAM/Colombia).
-
Staphylococcus aureus: Patogenia y Resistencia en Adultos

Guía actualizada de Staphylococcus aureus: microbiología, virulencia, inmunidad innata, transmisión, diagnóstico y perlas PROA para adultos.
-
Profilaxis Pre Exposición. PrEP.

Descubre cómo PrEP puede ser tu aliado en la prevención del VIH. Lee nuestra guía completa y toma acción hoy.
